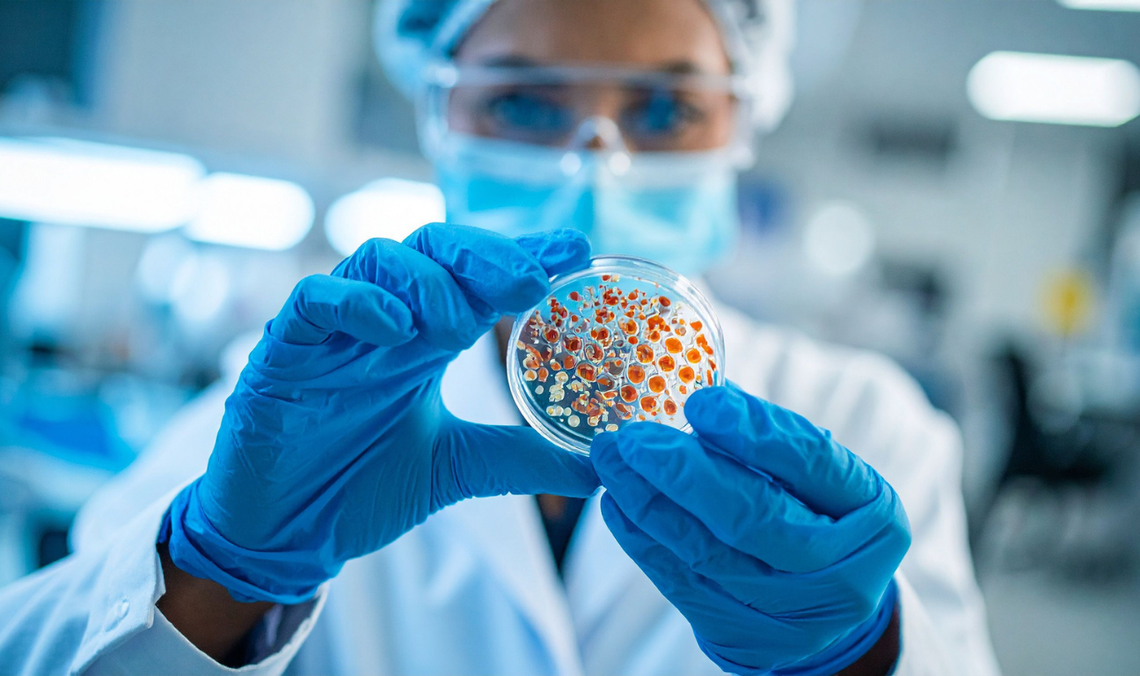
Przełomowa technologia naukowców z Gdańska! Wiedzą, jak walczyć z wirusem Zika Przełomowa technologia naukowców z Gdańska! Wiedzą, jak walczyć z wirusem Zika

Co to jest wirus Zika i dlaczego wciąż stanowi zagrożenie?
Wirus Zika to patogen przenoszony głównie przez komary z rodzaju Aedes. Dla większości zakażonych przebieg choroby jest łagodny, a często nawet całkowicie bezobjawowy. Problem w tym, że gdy wirus Zika zaatakuje kobietę w ciąży – zakażenie prowadzi do groźnych wad wrodzonych u dziecka.
Do dziś nie ma dostępnej szczepionki przeciwko wirusowi Zika. Większość projektów badawczych znajduje się dopiero na etapie wczesnych badań klinicznych. To właśnie dlatego wynalazek pomorskich naukowców to tak ważna wiadomość – może on przyspieszyć prace nad skuteczną profilaktyką.
CZYTAJ TEŻ: Bez skalpela i sekcji zwłok. Trójmiejska metoda przełomem w kryminalistyce
Przełomowa technologia z Gdańska – jak to działa?
Zespół z Międzyuczelnianego Wydziału Biotechnologii UG i GUMed opracował rozwiązanie oparte na tzw. cząsteczkach wirusopodobnych (VLP) – strukturach, które "udają" prawdziwy wirus, ale nie są zakaźne. Dzięki temu mogą pobudzić układ odpornościowy do wytworzenia ochrony, nie stwarzając przy tym ryzyka dla pacjenta.
Kluczową zaletą opracowanej technologii jest bezpieczeństwo i niższe koszty produkcji. Centrum Transferu Technologii Uniwersytetu Gdańskiego podkreśla, że produkcja rekombinowanych antygenów nie wymaga pracy z żywym wirusem, co znacząco obniża ryzyko i upraszcza cały proces.
Kim są naukowcy z Gdańska stojący za przełomem?
Pracami zespołu kierowała dr hab. Ewelina Król, prof. UG, wspierana przez prof. dr hab. Bogusława Szewczyka, dr Gabrielę Brzuską oraz dr Annę Czarnotą. To doświadczeni specjaliści z Międzyuczelnianego Wydziału Biotechnologii, który łączy potencjał Uniwersytetu Gdańskiego i Gdańskiego Uniwersytetu Medycznego.
Warto podkreślić, że pomorskie uczelnie od lat zajmują czołowe miejsca w rankingach naukowych. Współpraca pomiędzy tymi ośrodkami przynosi efekty nie tylko w formie publikacji, ale również konkretnych rozwiązań, które mogą wpłynąć na zdrowie i bezpieczeństwo ludzi na całym świecie.
Co dalej? Droga od patentu do szczepionki
Droga do powszechnie dostępnej szczepionki wciąż jest długa. Teraz przed zespołem z Gdańska kolejne etapy prac, a później - jeśli wszystko pójdzie zgodnie z planem - badania kliniczne z udziałem ludzi. Dopiero po przejściu tych wszystkich faz i uzyskaniu pozytywnych wyników szczepionka mogłaby trafić do powszechnego użytku.
Niemniej patent to fundament, który chroni wynalazek i daje naukowcom możliwość dalszego rozwoju technologii oraz komercjalizacji rozwiązania.
Pomorze dumne ze swoich naukowców
Sukces gdańskiego zespołu biotechnologów pokazuje, że badania prowadzone na pomorskich uczelniach mają realne znaczenie i są dostrzegane na poziomie europejskim. To efekt wieloletniej pracy naukowej, która coraz częściej przekłada się na konkretne rozwiązania.
Trójmiasto – obok turystyki, kultury i sektora IT – coraz wyraźniej zaznacza swoją pozycję jako ośrodek badań medycznych i biotechnologicznych. Osiągnięcia trójmiejskich zespołów badawczych regularnie trafiają do międzynarodowego obiegu naukowego.
A Ty, co sądzisz o najnowszym osiągnięciu pomorskich naukowców? Podziel się swoją opinią w komentarzach! Jeśli artykuł Cię zaciekawił, udostępnij go znajomym i śledź "Zawsze Pomorze", żeby być na bieżąco z najważniejszymi wiadomościami z regionu.

Napisz komentarz
Komentarze